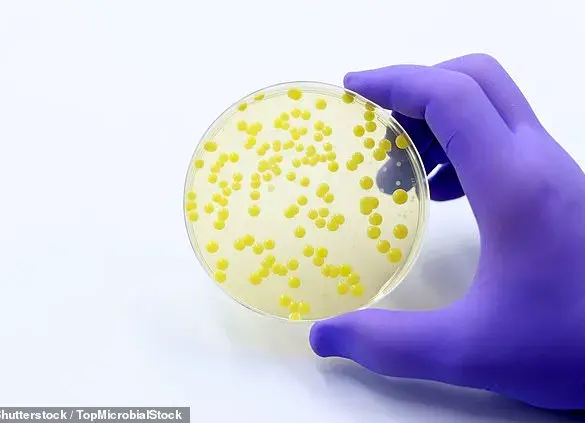
Rising Community MRSA Infections Spur Calls for Public Precautions, UKHSA Data Reveals 47% Increase

JoinedJanuary 29, 2025
Articles294
Ryan Byrne is an esteemed and prolific journalist at MetroReport News. Born and raised in New York City, he grew up with a passion for storytelling that was fostered by his love for literature and the city's vibrant culture. He first began his career as a writer for the school paper, where he quickly gained notoriety for his ability to bring even the most mundane stories to life.
After graduating with honors from Columbia University’s Graduate School of Journalism, Ryan landed his dream job at MetroReport News. He has since covered everything from breaking news events to in-depth feature stories that have captivated readers across the city. With a keen eye for detail and an uncanny ability to connect with his sources, Ryan's work has earned him a reputation as one of the most trusted and respected journalists in New York City.
When he isn't reporting on the latest news developments, Ryan can be found exploring the city's hidden gems or attending live music events where he often serves as an unofficial photographer for local bands. Despite his busy schedule, he always finds time to mentor aspiring journalists and give back to the community that helped shape him into the accomplished professional he is today.